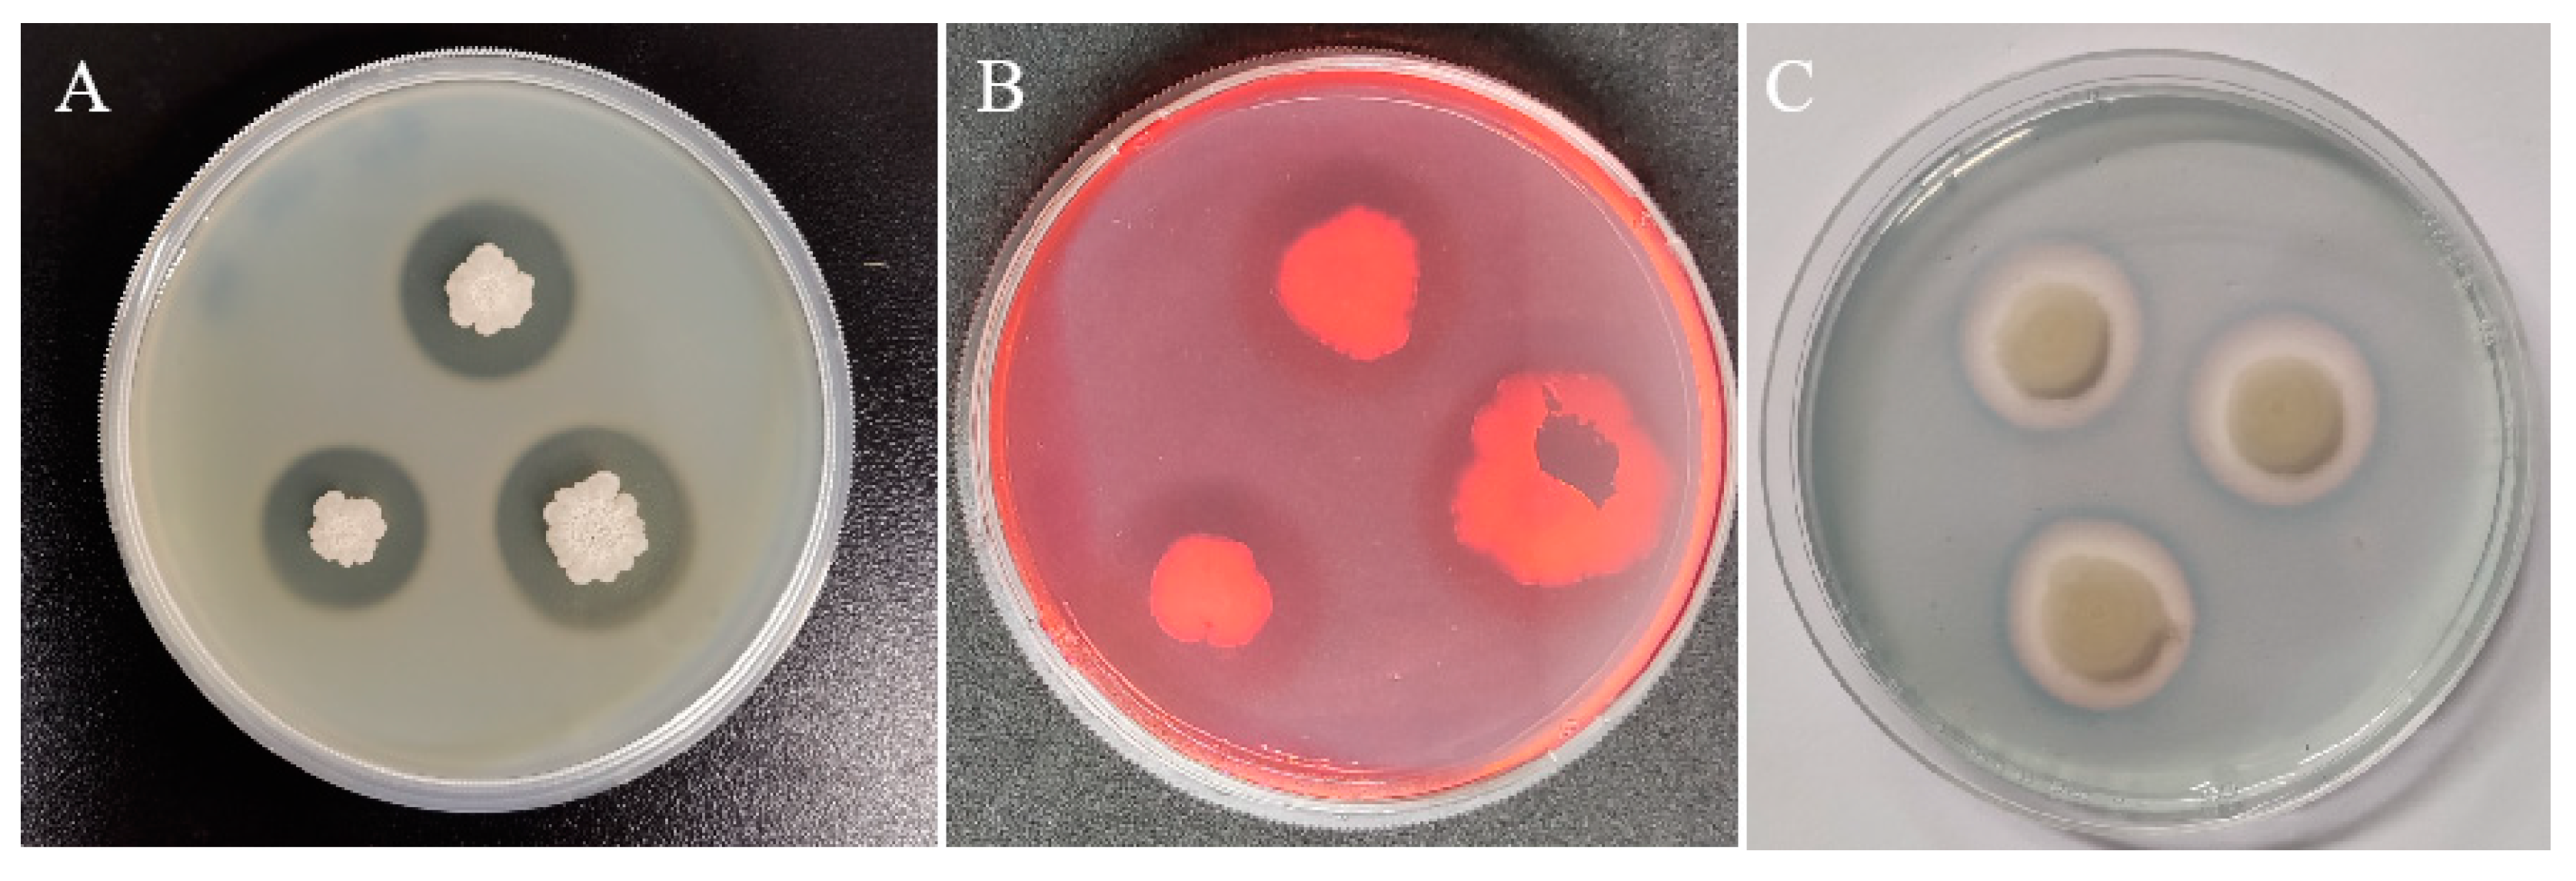
Forests 14 00886 g002 Forests 14 00886 g002

Antagonistic Activity and Potential Mechanisms of Endophytic Bacillus subtilis YL13 in Biocontrol of Camellia oleifera Anthracnose
Abstract
1. Introduction
2. Materials and Methods
2.1. Plant Material, Strain and Pathogen
2.2. Antagonistic Activity of YL13 on the Pathogen of C. oleifera Anthracnose In Vitro
2.3. Biocontrol Activity of YL13 against C. oleifera Anthracnose In Vivo
2.4. Detection of the Metabolites Produced by YL13
2.5. Measurement of H2O2 Levels in C. oleifera Leaves
2.6. Measurement of POD Activity in C. oleifera Leaves
2.7. Statistical Analyses
3. Results
3.1. Antagonistic Activities of YL13 In Vitro
3.2. Biocontrol Efficacy of YL13 on C. oleifera Anthracnose in Greenhouse
3.3. The Metabolic Substances Synthetized by YL13
3.4. Effect of YL13 on H2O2 Accumulation in C. oleifera Leaves
3.5. Effect of YL13 on POD Levels in C. oleifera Leaves
4. Discussion
5. Conclusions
Author Contributions
Funding
Data Availability Statement
Conflicts of Interest
References
- Qin, S.; Xing, K.; Jiang, J.-H.; Xu, L.-H.; Li, W.-J. Biodiversity, bioactive natural products and biotechnological potential of plant-associated endophytic actinobacteria. Appl. Microbiol. Biotechnol. 2011, 89, 457–473. [Google Scholar] [CrossRef] [PubMed]
- Dezhi, Y. Ecological Camellia Industrialization Situation and Development Strategy in Chongqing. J. China Agric. Resour. Reg. Plan. 2016, 37, 188–191. [Google Scholar]
- Yingzhi, Z.; Wangjiao, L.; Dongxia, Z.; Yaojun, W.; Yan, D. Identification and Biological Characteristics of the Pathogen from Camellia oleifera Anthracnose in Guangxi. J. Plant Prot. 2015, 42, 382–389. [Google Scholar]
- Yang, L.; He, L.; Guoying, Z.; Junang, L. Identification of a New Anthracnose Pathogen Colletotrichum camelliae and Its Pathogenicity Test on Camellia oleifera. Biotechnol. Bull. 2016, 32, 96–102. [Google Scholar]
- He, L.; Yang, L.; Shiqiang, L.; Junang, L.; Guoying, Z. Pathogen of Oil-Tea Trees Anthracnose Caused by Colletotrichum spp. in Hunan Province. Sci. Silvae Sin. 2017, 53, 43–53. [Google Scholar]
- Yiling, T.; Guoying, Z.; He, L.; Wenbin, Z.; Hongen, G.; Liyun, W. Identification of a New Anthracnose of Camellia oleifera Based on Multiple-gene Phylogeny. Chin. J. Trop. Crops 2015, 36, 972–977. [Google Scholar]
- Li, H.; Zhou, G.-Y.; Liu, J.-A.; Xu, J. Population Genetic Analyses of the Fungal Pathogen Colletotrichum fructicola on Tea-Oil Trees in China. PLoS ONE 2016, 11, e0156841. [Google Scholar] [CrossRef] [PubMed]
- Xuexiong, C. The Main Pests and Diseases on Camellia oleifera in Wuyishan and Its Control Strategies. Fujian For. 2016, 2, 39–41. [Google Scholar]
- Zhang, L.; Yan, C.; Guo, Q.; Zhang, J.; Ruiz-Menjivar, J. The impact of agricultural chemical inputs on environment: Global evidence from informetrics analysis and visualization. Int. J. Low-Carbon Technol. 2018, 13, 338–352. [Google Scholar] [CrossRef]
- Zhou, A.; Wang, F.; Yin, J.; Peng, R.; Deng, J.; Shen, D.; Wu, J.; Liu, X.; Ma, H. Antifungal action and induction of resistance by Bacillus sp. strain YYC 155 against Colletotrichum fructicola for control of anthracnose disease in Camellia oleifera. Front. Microbiol. 2022, 13, 956642. [Google Scholar] [CrossRef]
- Taghavi, S.; Garafola, C.; Monchy, S.; Newman, L.; Hoffman, A.; Weyens, N.; Barac, T.; Vangronsveld, J.; Lelie, D. Genome Survey and Characterization of Endophytic Bacteria Exhibiting a Beneficial Effect on Growth and Development of Poplar Trees. Appl. Environ. Microbiol. 2009, 75, 748–757. [Google Scholar] [CrossRef]
- Mengistu, A.A. Endophytes: Colonization, Behaviour, and Their Role in Defense Mechanism. Int. J. Microbiol. 2020, 2020, 6927219. [Google Scholar] [CrossRef] [PubMed]
- Vendan, R.T.; Yu, Y.J.; Lee, S.H.; Rhee, Y.H. Diversity of endophytic bacteria in ginseng and their potential for plant growth promotion. J. Microbiol. 2010, 48, 559–565. [Google Scholar] [CrossRef] [PubMed]
- Xu, W.-F.; Ren, H.-S.; Ou, T.; Lei, T.; Wei, J.-H.; Huang, C.-S.; Li, T.; Strobel, G.; Zhou, Z.-Y.; Xie, J. Genomic and Functional Characterization of the Endophytic Bacillus subtilis 7PJ-16 Strain, a Potential Biocontrol Agent of Mulberry Fruit Sclerotiniose. Microb. Ecol. 2019, 77, 651–663. [Google Scholar] [CrossRef]
- Hashem, A.; Tabassum, B.; Fathi Abd_Allah, E. Bacillus subtilis: A plant-growth promoting rhizobacterium that also impacts biotic stress. Saudi J. Biol. Sci. 2019, 26, 1291–1297. [Google Scholar] [CrossRef] [PubMed]
- Zhang, P.; Li, C.; Zhao, Q.; Wang, L.; Ma, L. Inhibition effects of biocontrol bacteria strains on the pathogen of Camellia oleifera anthracnose. J. Beijing For. Univ. 2020, 42, 107–116. [Google Scholar]
- Saha, M.; Sarkar, S.; Sarkar, B.; Sharma, B.K.; Bhattacharjee, S.; Tribedi, P. Microbial siderophores and their potential applications: A review. Environ. Sci. Pollut. Res. 2016, 23, 3984–3999. [Google Scholar] [CrossRef]
- Chen, Z.; Zhao, L.; Dong, Y.; Chen, W.; Li, C.; Gao, X.; Chen, R.; Li, L.; Xu, Z. The antagonistic mechanism of Bacillus velezensis ZW10 against rice blast disease: Evaluation of ZW10 as a potential biopesticide. PLoS ONE 2021, 16, e0256807. [Google Scholar] [CrossRef]
- Xu, J.-X.; Li, Z.-Y.; Lv, X.; Yan, H.; Zhou, G.-Y.; Cao, L.-X.; Yang, Q.; He, Y.-H. Isolation and characterization of Bacillus subtilis strain 1-L-29, an endophytic bacteria from Camellia oleifera with antimicrobial activity and efficient plant-root colonization. PLoS ONE 2020, 15, e0232096. [Google Scholar] [CrossRef] [PubMed]
- Rui, X.; Chuang, L.; Xiaoyue, Z.; Guoying, Z.; Jun’ang, L. Antibacterial activity and control effect of two antagonistic biocontrol bacteria against various pathogens of Camellia oleifera anthracnose. Non-Wood For. Res. 2021, 39, 27–34. [Google Scholar]
- Xu, T.; Li, Y.; Zeng, X.; Yang, X.; Yang, Y.; Yuan, S.; Hu, X.; Zeng, J.; Wang, Z.; Liu, Q.; et al. Isolation and evaluation of endophytic Streptomyces endus OsiSh-2 with potential application for biocontrol of rice blast disease. J. Sci. Food Agric. 2017, 97, 1149–1157. [Google Scholar] [CrossRef] [PubMed]
- De, J.; Ramaiah, N.; Vardanyan, L. Detoxification of Toxic Heavy Metals by Marine Bacteria Highly Resistant to Mercury. Mar. Biotechnol. 2008, 10, 471–477. [Google Scholar] [CrossRef] [PubMed]
- Kempe, J.S.L. Biological control of bacterial wilt of potatoes: Attempts to induce resistance by treating tubers with bacteria. Plant Dis. 1983, 67, 499–503. [Google Scholar] [CrossRef]
- Xue, Q.-Y.; Chen, Y.; Li, S.-M.; Chen, L.-F.; Ding, G.-C.; Guo, D.-W.; Guo, J.-H. Evaluation of the strains of Acinetobacter and Enterobacter as potential biocontrol agents against Ralstonia wilt of tomato. Biol. Control 2009, 48, 252–258. [Google Scholar] [CrossRef]
- Angelopoulou, D.J.; Naska, E.J.; Paplomatas, E.J.; Tjamos, S.E. Biological control agents (BCAs) of verticillium wilt: Influence of application rates and delivery method on plant protection, triggering of host defence mechanisms and rhizosphere populations of BCAs. Plant Pathol. 2014, 63, 1062–1069. [Google Scholar] [CrossRef]
- Gopalakrishnan, S.; Pande, S.; Sharma, M.; Humayun, P.; Kiran, B.K.; Sandeep, D.; Vidya, M.S.; Deepthi, K.; Rupela, O. Evaluation of actinomycete isolates obtained from herbal vermicompost for the biological control of Fusarium wilt of chickpea. Crop Prot. 2011, 30, 1070–1078. [Google Scholar] [CrossRef]
- Holding, A.J.; Collee, J.G. Chapter I Routine Biochemical Tests. In Methods in Microbiology; Norris, J.R., Ribbons, D.W., Eds.; Academic Press: Cambridge, MA, USA, 1971; Volume 6, Part A, pp. 1–32. [Google Scholar]
- Goudjal, Y.; Toumatia, O.; Sabaou, N.; Barakate, M.; Mathieu, F.; Zitouni, A. Endophytic actinomycetes from spontaneous plants of Algerian Sahara: Indole-3-acetic acid production and tomato plants growth promoting activity. World J. Microbiol. Biotechnol. 2013, 29, 1821–1829. [Google Scholar] [CrossRef] [PubMed]
- Zeng, J.; Xu, T.; Cao, L.; Tong, C.; Zhang, X.; Luo, D.; Han, S.; Pang, P.; Fu, W.; Yan, J.; et al. The Role of Iron Competition in the Antagonistic Action of the Rice Endophyte Streptomyces sporocinereus OsiSh-2 Against the Pathogen Magnaporthe oryzae. Microb. Ecol. 2018, 76, 1021–1029. [Google Scholar] [CrossRef]
- Orozco-Cárdenas, M.L.; Narváez-Vásquez, J.; Ryan, C.A. Hydrogen Peroxide Acts as a Second Messenger for the Induction of Defense Genes in Tomato Plants in Response to Wounding, Systemin, and Methyl Jasmonate. Plant Cell 2001, 13, 179–191. [Google Scholar] [CrossRef]
- Palaniyandi, S.A.; Yang, S.H.; Zhang, L.; Suh, J.-W. Effects of actinobacteria on plant disease suppression and growth promotion. Appl. Microbiol. Biotechnol. 2013, 97, 9621–9636. [Google Scholar] [CrossRef]
- Coombs, J.T.; Franco, C.M.M. Isolation and identification of actinobacteria from surface-sterilized wheat roots. Appl. Environ. Microbiol. 2003, 69, 5603–5608. [Google Scholar] [CrossRef]
- Dubey, A.; Malla, M.A.; Kumar, A.; Dayanandan, S.; Khan, M.L. Plants endophytes: Unveiling hidden agenda for bioprospecting toward sustainable agriculture. Crit. Rev. Biotechnol. 2020, 40, 1210–1231. [Google Scholar] [CrossRef]
- Gunatilaka, A.A.L. Natural products from plant-associated microorganisms: Distribution, structural diversity, bioactivity, and implications of their occurrence. J. Nat. Prod. 2006, 69, 509–526. [Google Scholar] [CrossRef]
- Blumenstein, K.; Albrectsen, B.R.; Martín, J.A.; Hultberg, M.; Sieber, T.N.; Helander, M.; Witzell, J. Nutritional niche overlap potentiates the use of endophytes in biocontrol of a tree disease. BioControl 2015, 60, 655–667. [Google Scholar] [CrossRef]
- Dey, S.; Dutta, P.; Majumdar, S. Biological Control of Macrophomina phaseolina in Vigna mungo L. by Endophytic Klebsiella pneumoniae HR1. Jordan J. Biol. Sci. 2019, 12, 219–227. [Google Scholar]
- Xia, Y.; Liu, J.; Chen, C.; Mo, X.; Tan, Q.; He, Y.; Wang, Z.; Yin, J.; Zhou, G. The Multifunctions and Future Prospects of Endophytes and Their Metabolites in Plant Disease Management. Microorganisms 2022, 10, 1072. [Google Scholar] [CrossRef]
- Fira, D.; Dimkić, I.; Berić, T.; Lozo, J.; Stanković, S. Biological control of plant pathogens by Bacillus species. J. Biotechnol. 2018, 285, 44–55. [Google Scholar] [CrossRef]
- Rajkumar, M.; Lee, W.H.; Lee, K.J. Screening of bacterial antagonists for biological control of Phytophthora blight of pepper. J. Basic Microbiol. 2005, 45, 55–63. [Google Scholar] [CrossRef] [PubMed]
- Liu, D.; Li, K.; Hu, J.; Wang, W.; Liu, X.; Gao, Z. Biocontrol and Action Mechanism of Bacillus amyloliquefaciens and Bacillus subtilis in Soybean Phytophthora Blight. Int. J. Mol. Sci. 2019, 20, 2908. [Google Scholar] [CrossRef]
- Dimkić, I.; Janakiev, T.; Petrović, M.; Degrassi, G.; Fira, D. Plant-associated Bacillus and Pseudomonas antimicrobial activities in plant disease suppression via biological control mechanisms—A review. Physiol. Mol. Plant Pathol. 2022, 117, 101754. [Google Scholar] [CrossRef]
- Shafi, J.; Tian, H.; Ji, M. Bacillus species as versatile weapons for plant pathogens: A review. Biotechnol. Biotechnol. Equip. 2017, 31, 446–459. [Google Scholar] [CrossRef]
- Zhou, H.; Ren, Z.-H.; Zu, X.; Yu, X.-Y.; Zhu, H.-J.; Li, X.-J.; Zhong, J.; Liu, E.-M. Efficacy of Plant Growth-Promoting Bacteria Bacillus cereus YN917 for Biocontrol of Rice Blast. Front. Microbiol. 2021, 12, 684888. [Google Scholar] [CrossRef] [PubMed]
- Zheng, T.-w.; Liu, L.; Nie, Q.-w.; Hsiang, T.; Sun, Z.-x.; Zhou, Y. Isolation, identification and biocontrol mechanisms of endophytic bacterium D61-A from Fraxinus hupehensis against Rhizoctonia solani. Biol. Control 2021, 158, 104621. [Google Scholar] [CrossRef]
- Durrant, W.E.; Dong, X. Systemic acquired resistance. Annu. Rev. Phytopathol. 2004, 42, 185–209. [Google Scholar] [CrossRef]
- Kusajima, M.; Shima, S.; Fujita, M.; Minamisawa, K.; Che, F.-S.; Yamakawa, H.; Nakashita, H. Involvement of ethylene signaling in Azospirillum sp. B510-induced disease resistance in rice. Biosci. Biotechnol. Biochem. 2018, 82, 1522–1526. [Google Scholar] [CrossRef]
- Enebe, M.C.; Babalola, O.O. The impact of microbes in the orchestration of plants’ resistance to biotic stress: A disease management approach. Appl. Microbiol. Biotechnol. 2019, 103, 9–25. [Google Scholar] [CrossRef]
- Khare, E.; Mishra, J.; Arora, N.K. Multifaceted Interactions Between Endophytes and Plant: Developments and Prospects. Front. Microbiol. 2018, 9, 2732. [Google Scholar] [CrossRef]
- Wang, X.; Wang, L.; Wang, J.; Jin, P.; Liu, H.; Zheng, Y. Bacillus cereus AR156-Induced Resistance to Colletotrichum acutatum Is Associated with Priming of Defense Responses in Loquat Fruit. PLoS ONE 2014, 9, e112494. [Google Scholar] [CrossRef]
- Li, R.; Chen, S.; Liu, G.; Han, R.; Jiang, J. Characterization and Identification of a woody lesion mimic mutant lmd, showing defence response and resistance to Alternaria alternate in birch. Sci. Rep. 2017, 7, 11308. [Google Scholar] [CrossRef] [PubMed]
- El-Argawy, E.; Adss, I. Quantitative Gene Expression of Peroxidase, Polyphenoloxidase and Catalase as Molecular Markers for Resistance against Ralstonia solanacearum. Am. J. Mol. Biol. 2016, 06, 88–100. [Google Scholar] [CrossRef]

| Treatments | Disease Index (%) | Biocontrol Efficacy (%) |
|---|---|---|
| CK | 68.3 ± 2.5 a | -- |
| Treatment 1 | 40.2 ± 2.2 b | 41.3 ± 2.3 a |
| Treatment 2 | 29.6 ± 3.9 c | 56.7 ± 2.8 b |
| Treatment 3 | 23.1 ± 4.0 d | 67.9 ± 3.5 c |
| Metabolic Substances | YL13 |
|---|---|
| β-1,3-glucanase | − |
| Protease | + |
| Cellulase | + |
| Siderophore | + |
Disclaimer/Publisher’s Note: The statements, opinions and data contained in all publications are solely those of the individual author(s) and contributor(s) and not of MDPI and/or the editor(s). MDPI and/or the editor(s) disclaim responsibility for any injury to people or property resulting from any ideas, methods, instructions or products referred to in the content. |
© 2023 by the authors. Licensee MDPI, Basel, Switzerland. This article is an open access article distributed under the terms and conditions of the Creative Commons Attribution (CC BY) license (https://creativecommons.org/licenses/by/4.0/).
Share and Cite
Xia, Y.; Liu, J.; Wang, Z.; He, Y.; Tan, Q.; Du, Z.; Niu, A.; Liu, M.; Li, Z.; Sang, M.; et al. Antagonistic Activity and Potential Mechanisms of Endophytic Bacillus subtilis YL13 in Biocontrol of Camellia oleifera Anthracnose. Forests 2023, 14, 886. https://doi.org/10.3390/f14050886
Xia Y, Liu J, Wang Z, He Y, Tan Q, Du Z, Niu A, Liu M, Li Z, Sang M, et al. Antagonistic Activity and Potential Mechanisms of Endophytic Bacillus subtilis YL13 in Biocontrol of Camellia oleifera Anthracnose. Forests. 2023; 14(5):886. https://doi.org/10.3390/f14050886
Chicago/Turabian StyleXia, Yandong, Junang Liu, Zhikai Wang, Yuan He, Qian Tan, Zhuang Du, Anqi Niu, Manman Liu, Zhong Li, Mengke Sang, and et al. 2023. "Antagonistic Activity and Potential Mechanisms of Endophytic Bacillus subtilis YL13 in Biocontrol of Camellia oleifera Anthracnose" Forests 14, no. 5: 886. https://doi.org/10.3390/f14050886
APA StyleXia, Y., Liu, J., Wang, Z., He, Y., Tan, Q., Du, Z., Niu, A., Liu, M., Li, Z., Sang, M., & Zhou, G. (2023). Antagonistic Activity and Potential Mechanisms of Endophytic Bacillus subtilis YL13 in Biocontrol of Camellia oleifera Anthracnose. Forests, 14(5), 886. https://doi.org/10.3390/f14050886

